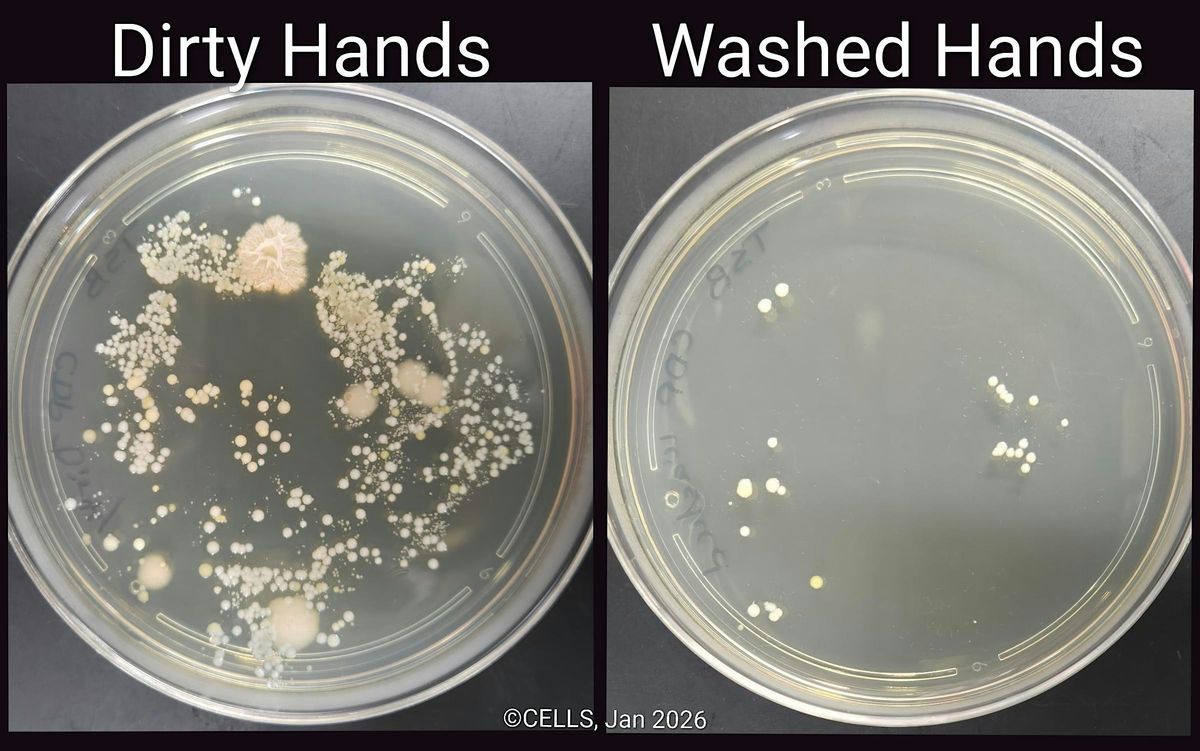

About this Event
🥼 Lab (and Flu Season) Ready
Master the safety procedures of a professional microbiology lab.
Think you know how to stay safe in a lab, or a grocery store during flu season? It’s one thing to hear about hygiene; it’s another to visualize the microbes hitching a ride on your hands. In this BioFUNdamentals session we nvite you to step into the role of a lab scientist to master the technical skills required to navigate the "invisible world" safely.
🧪 Lab Orientation & PPE
In any science research setting, your first priority is safety. You will learn to use Personal Protective Equipment (PPE) properly. Through a Safety Scavenger Hunt, you’ll get familiar with the lab environment, identifying the safety tools of the lab and learning the strict safety rules that keep us and our environment safe.
🧫 The Bio-Audit: The Hands Washing Test
Did you know that our hands are one of the most common vectors for transmitting disease causing microbes and viruses, especially during flu and cold season? You will form a hypothesis and use agar petri dishes to conduct a controlled experiment about the microbes living and hitching a ride on your hands.
- The Methodology: You will deposit microbes from your unwashed hands on an agar petri dish and then repeat the process after you follow a proper hands washing technique.
- The Data: After 1-3 days of incubation, we will send you high-resolution digital photos of your cultures. Analyzing the microbial "landscape" of your own skin provides a definitive, visual answer to how well you mastered the hand washing protocol.
🧤 The Glove Challenge: "Zero Transfer"
Proper glove removal (doffing) is a critical skill in both lab research settings, medical settings (including providing first aid), and any messy home project involving gloves. We will teach you how to safely remove your gloves and then put your technique to the test: we will coat your gloves in a safe paint to simulate a contaminant. Your objective? Remove the gloves without a single speck of transfer to your skin. It is a test of precision, dexterity, and situational awareness.
🔬 Small Group Training
Limited Enrollment: 6 Students Only! This allows for productive discussions, personalized attention, and a safe, authentic lab environment.
The BioFUNdamentals Series: Master the Tools of the Biotech Revolution
Age 13 to Adult | No Prior Experience Required | Verifyable Skill-Building
Biology is no longer just a natural science, it is the world’s most powerful technology. Whether you are a curious student, tired of boring lectures or looking to dominate college applications, a professional eyeing a career pivot, or a lifelong learner, BioFUNdamentals provides engaging, hands-on experiments usually reserved for university labs and industry Research & Development centers.
The Experience
- Scientific Equipment: Move beyond theory. You will master real sceiece tools: precision micropipettes, DNA thermal cyclers (PCR), gel electrophoresis, etc.
- Applied Science: Perform experiments including genetically engineering bacteria, protein micro-manufacturing and purification and more.
- Expert Mentorship: Learn with a professional scientist passionate about teaching others in a lab environment designed to improve bioliteracy, empower sitizens in the Age of Biology, and provide training for the future BioEngineer.
The BioFUN Advantage: Your Digital Portfolio
We believe skills should be visible and verifiable. Our curriculum is mapped to 55 specific laboratory competencies.
- 55 Verifiable Skills: Every technique you master, from DNA Extraction to Bacterial Transformation, is logged in our Digital Skill Portal.
- A Competitive Edge: Use your verifyable skills on your resume, or college applications. Stand out to recruiters and admissions officers with documented, hands-on lab hours.
- Modular Flexibility: Life is busy. Our program is designed for maximum autonomy; complete classes in any order and track your progress through our mobile app.
Event Venue & Nearby Stays
4539 Metropolitan Ct, 4539 Metropolitan Court, Frederick, United States
USD 25.00










